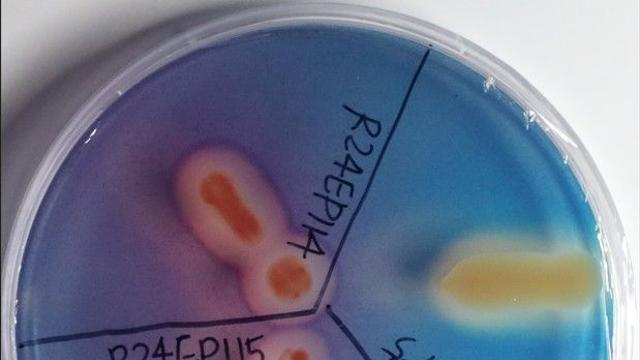
thumbimg

⚡ 뉴스 pick
- 12월 17일 장중 달러 엔 유로 원화 대비 강세
- 2025.12.17 [투어코리아]
- 노스페이스 ‘눈속임 패딩’ 팩트 체크
- 2025.12.17 [일요시사]
- 호남권생물자원관, 식물 생장 촉진 세균 46종 신규 확인
- 2025.12.17 [연합뉴스]
- “이렇게 운영하면 뭐가 남나요?”...아이온2, 엔씨 서비스 변화의 바람
- 2025.12.17 [게임와이]
- '내란선동·공무집행방해 혐의' 황교안 재판 내달 22일 시작
- 2025.12.17 [연합뉴스]
- “제주삼다수 지하수, 평균 31년 걸려 형성…국제 학술지 게재”
- 2025.12.17 [디지틀조선일보]
- 영혼각인 공략 가이드, 전투력보다 중요한 진짜 스펙업의 기준
- 2025.12.17 [게임와이]
- 여수·순천·광양·나주 29개면, 지방소멸 '고위험'
- 2025.12.17 [연합뉴스]
- 부산 축제·행사 안전관리 대폭 강화... 관련 조례 2건 본회의 통과
- 2025.12.17 [중도일보]
- 폴라리스AI, 액손 차세대 바디캠 '워크포스 미니' 국내 공식 공급…민간 산업 안전시장 공략 '본격화'
- 2025.12.17 [프라임경제]
- 롯데이노베이트, '아이멤버'로 기업용 AI 대외 시장 공략
- 2025.12.17 [아주경제]
- 인천시, 전국 지자체 최초 '태양광 외부사업' 등록 승인 쾌거
- 2025.12.17 [중도일보]
- AIA생명·ABL생명·메리츠화재
- 2025.12.17 [프라임경제]
- BMW 코리아, 환경교육 혁신하는 '넥스트 그린 교원 직무연수' 개설
- 2025.12.17 [뉴스웨이]
- 팔도 '상남자라면 마늘 육개장' 선보여
- 2025.12.17 [연합뉴스]
- 국힘 당무위 '김종혁 징계' 권고 여진…김종혁 "윤리위 수용시 가처분" 반발
- 2025.12.17 [모두서치]
- 심장 몸 밖에 나온 채 태어난 '서린이'…"힘 합쳐 살렸다"
- 2025.12.17 [모두서치]
- 정청래 "3대 특검 미진한 부분 너무 많아…2차 특검 당 총의 모을 것"
- 2025.12.17 [모두서치]
- "디지털 헬스로 진료 질 높여"…'일만사' 운영 경험 공유
- 2025.12.17 [모두서치]
- 나경원 "당원게시판 문제, 한동훈 사과하고 정리해야"
- 2025.12.17 [모두서치]